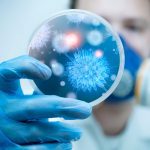

Más del 1% de las embarazadas expuestas al Mal de Chagas
- Redacción
- 25 abril, 2025
- Salud
- bservatorio Chagas, embarazada, Federación Argentina de Cardiología, Mal de Chagas, Portada
- 0 Comments
El Observatorio Chagas destacó que más del 1% de las mujeres embarazadas en Argentina se expusieron a esta enfermedad. Se trata de una enfermedad endémica de América latina, aunque se registran casos en otras partes del mundo. Lo padecen 7 millones en todo el mundo. La miocardiopatía chagásica es una enfermedad crónica desatendida.
La enfermedad de Chagas se transmite por medio del parásito Trypanosoma Cruzi y de su vector (Vinchuca). Desde la Federación Argentina de Cardiología (FAC) por medio de su Comité de Chagas se pone el acento en la prevención. Como también hacen un llamado a la acción conjunta de los diferentes gobiernos, los establecimientos de salud y su personal. Y asimismo a la población en general para mejorar los diagnósticos y aumentar la prevención.
Se estima que en el mundo 7 millones de personas padecen de esta enfermedad y el 70% de ella no sabe que lo tiene. En el caso de Argentina, un millón y medio de personas viven con Chagas.
“El diagnóstico temprano y oportuno es una pieza clave en la prevención de problemas de salud aún mayores, principalmente, del aparato cardiovascular. Que dicho sea de paso es la principal causa de morbi-mortalidad de estos pacientes”. Así lo indicó Jorge Tazar, presidente del Comité de Enfermedad de Chagas Mazza de la FAC.
El Observatorio Chagas se conforma por organizaciones, entre las cuales se encuentra la FAC. Y cuenta con el apoyo de la Federación Mundial del Corazón)
De su más reciente estudio se desprende que al menos el 1,1% de las mujeres embarazadas en Argentina presentan serología positiva para Chagas. Es decir que en análisis de laboratorio se detectaron anticuerpos contra el parásito causante de esta enfermedad. “Estos datos epidemiológicos nos movilizan nuevamente a la pesquisa de esta enfermedad en esta población. Más aún si se encuentran en una zona endémica”, señaló Tazar.
Además, en menores de 15 años, las pruebas serológicas dieron positivas para Chagas en un 1,2%.
“La comunidad médica cardiológica en general conoce acerca de la enfermedad de Chagas. Pero muchas veces, se arriba al diagnóstico cuando aparecieron complicaciones tales como Insuficiencia cardiaca, arritmias, accidente cerebro-vascular o necesidad de colocación de marcapasos. Es por eso que existe la necesidad de la difusión del conocimiento para llevar adelante entre todos las mejores estrategias para enfrentar esta enfermedad”.
Para los tratamientos de la enfermedad de Chagas existen diversos fármacos. Pero lo más importante es trabajar arduamente en la prevención eliminando todas aquellas condiciones que faciliten la reproducción de la vinchuca. Además, si se vive en zonas de alta incidencia, como ser el noroeste argentino, solicitar exámenes de laboratorio para detectar posible contagio es fundamental para tratar esta enfermedad en etapas tempranas.

Leave A Comment